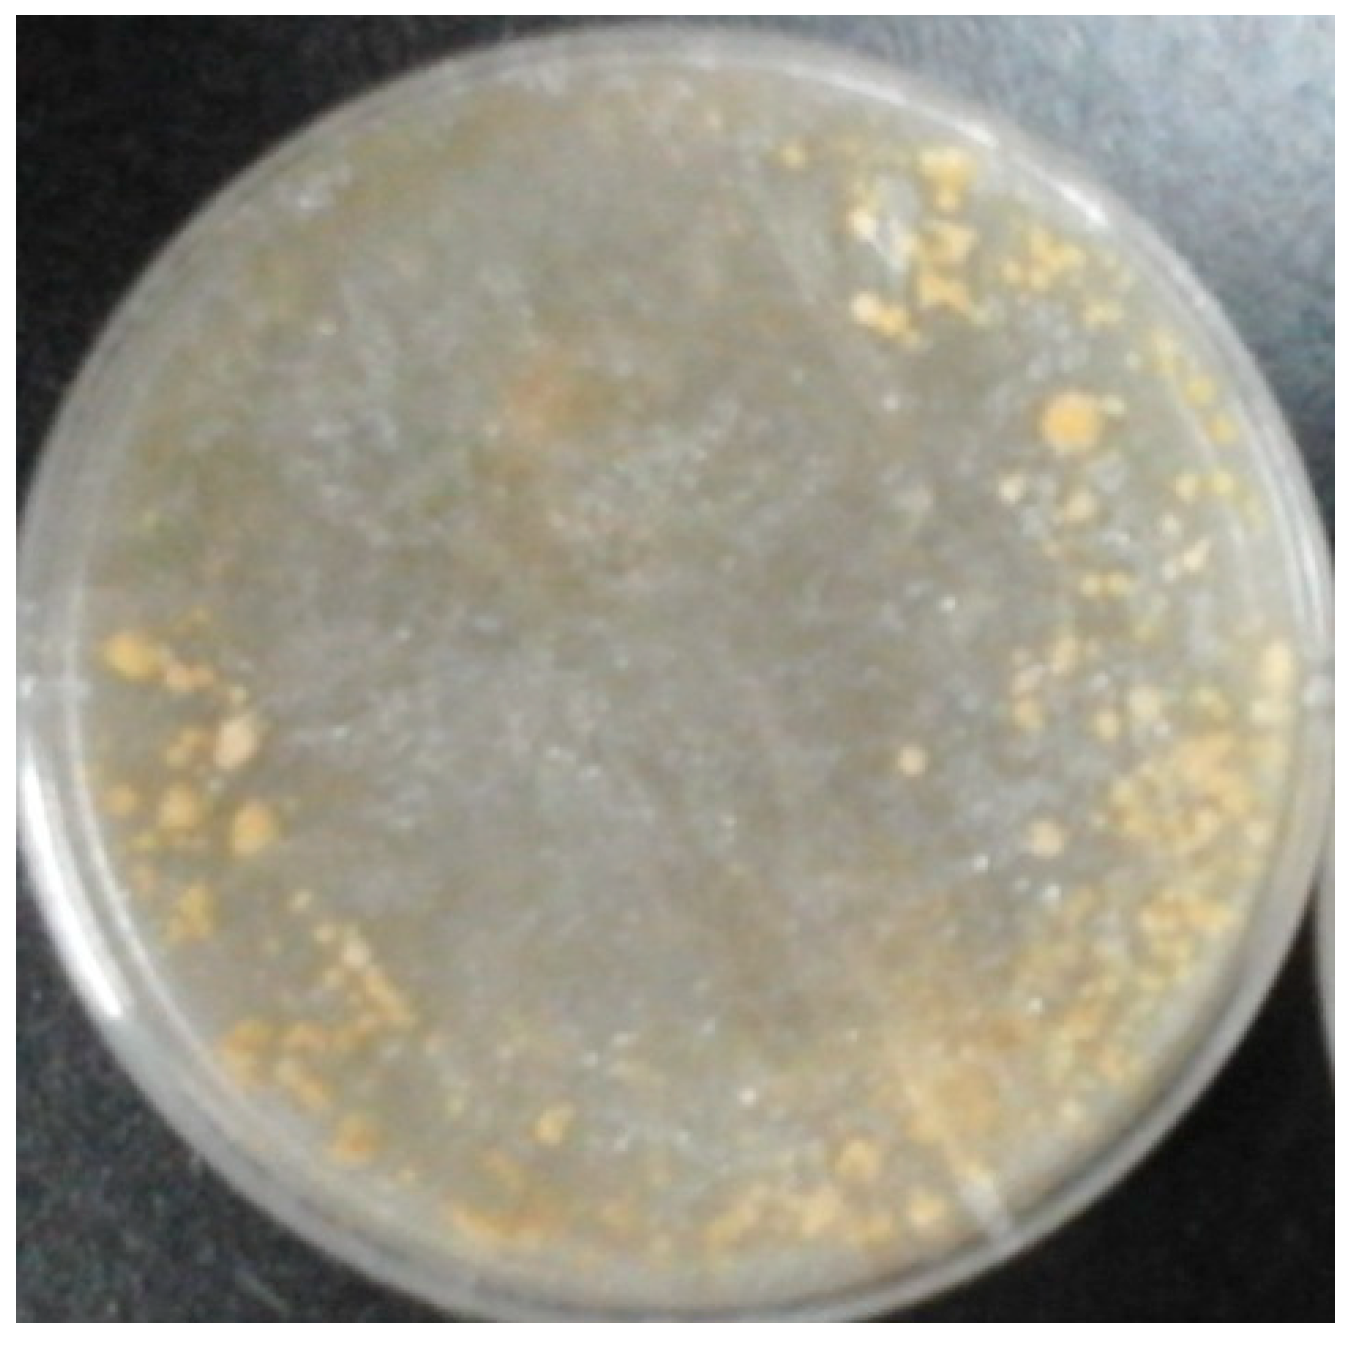
Molecules 24 01706 g001

Secondary Metabolites and Antiradical Activity of Liquid Fermentation of Morchella sp. Isolated from Southwest China
Abstract
:1. Introduction
2. Results
2.1. Identification of Strain
2.2. Isolation and Identification of Secondary Metabolites
2.3. Antiradical Activity of Compounds
3. Discussion
4. Materials and Methods
4.1. Isolation and Identification of Morchella sp. YDJ-ZY-1
4.2. Fermentation of Strain
4.3. Isolation and Identification of Metabolites
4.4. Antiradical Activity of Compounds
5. Conclusions
6. Patents
Author Contributions
Funding
Conflicts of Interest
References
- Bains, A.; Tripathi, A. Antioxidant and anti-inflammatory properties of wild mushrooms collected from Himachal Pradesh. World J. Pharm. Res. 2015, 4, 1507–1520. [Google Scholar]
- Liu, C.; Sun, Y.; Mao, Q.; Guo, X.; Li, P.; Liu, Y.; Xu, N. Characteristics and antitumor activity of Morchella esculenta polysaccharide extracted by pulsed electric field. Int. J. Mol. Sci. 2016, 17, 986. [Google Scholar] [CrossRef] [PubMed]
- Shameem, N.; Kamili, A.N.; Ahmad, M.; Masoodi, F.A.; Parray, J.A. Antimicrobial activity of crude fractions and morel compounds from wild edible mushrooms of North western Himalaya. Microb. Pathogenesis. 2017, 105, 356–360. [Google Scholar] [CrossRef] [PubMed]
- Tietel, Z.; Masaphy, S. True morels (Morchella)—Nutritional and phytochemical composition, health benefits and flavor: A review. Crit. Rev. Food Sci. Nutr. 2017, 58, 1888–1901. [Google Scholar] [CrossRef] [PubMed]
- Xiong, C.; Qiang, L.; Cheng, C.; Chen, Z.; Huang, W. Neuroprotective effect of crude polysaccharide isolated from the fruiting bodies of Morchella importuna against H2O2-induced PC12 cell cytotoxicity by reducing oxidative stress. Biomed. Pharmacother. 2016, 83, 569–576. [Google Scholar] [CrossRef] [PubMed]
- Ajmal, M.; Akram, A.; Ara, A.; Akhund, S.; Nayyar, B.G. Morchella esculenta: An edible and health beneficial mushroom. Pakistan J. Food Sci. 2015, 25, 71–78. [Google Scholar]
- Lee, S.R.; Roh, H.S.; Lee, S.; Park, H.B.; Jang, T.S.; Ko, Y.J.; Baek, K.H.; Kim, K.H. Bioactivity-guided isolation and chemical characterization of antiproliferative constituents from morel mushroom (Morchella esculenta) in human lung adenocarcinoma cells. J. Funct. Foods 2018, 40, 249–260. [Google Scholar] [CrossRef]
- Zhang, Q.; Wu, C.; Fan, G.; Li, T.; Sun, Y. Improvement of antioxidant activity of Morchella esculenta protein hydrolysate by optimized glycosylation reaction. CyTA J. Food 2018, 16, 238–246. [Google Scholar] [CrossRef]
- Li, Y.; Yuan, Y.; Lei, L.; Li, F.; Zhang, Y.; Chen, J.; Zhao, G.; Wu, S.; Yin, R.; Ming, J. Carboxymethylation of polysaccharide from Morchella angusticepes Peck enhances its cholesterol-lowering activity in rats. Carbohyd. Polym. 2017, 172, 85. [Google Scholar] [CrossRef] [PubMed]
- Ghandi, M.; Bayat, Y.; Teimuri-Mofrad, R. A novel method for the synthesis of formyl and hydroxymethyl derivatives of 3H-pyran-4-one. Org. Prep. Proced. 2003, 34, 525–530. [Google Scholar] [CrossRef]
- Teimuri-Mofrad, R.; Abrishami, F. Synthesis of some hydroxymethyl derivatives of 4H-pyran-4-ones via N–O bond cleavage. Asian J. Chem. 2008, 20, 1203–1210. [Google Scholar]
- Zheng, Y.; Lu, C.; Xu, L.; Zheng, Z.; Su, W.; Shen, Y. Chemical components from surface liquid fermented hericium erinaceus with cytotoxity investigations. Nat. Prod. Res. Devel. 2012, 24, 1703–1706. [Google Scholar]
- Qian, F.; Xu, G.; Du, S.; Li, M. Isolation and identification of two new pyrone compounds from the culture of herictum erinaceus. Acta Pharm. Sin. 1990, 522–525. [Google Scholar]
- Guo, J.; Zhang, J.; Wang, W.; Liu, T.; Xin, Z. Isolation and identification of bound compounds from corn bran and their antioxidant and angiotensin I-converting enzyme inhibitory activities. Eur. Food Res. Technol. 2015, 241, 37–47. [Google Scholar] [CrossRef]
- Gao, Y.; Huqiang, L.I.; Zhang, Z.; Xiaojun, L.I. Chemical constituents from an endophytic fungus Aspergillus sp. 12Y03 isolated from Perilla frutescens. Acta Bot. Boreal.-Occid. Sin. 2013, 33, 1473–1477. [Google Scholar]
- Tu, T.H.; Kim, H.J.; Yang, S.G.; Kim, J.K.; Kim, J.G. Linoleic acid rescues microglia inflammation triggered by saturated fatty acid. Biochem. Biophys. Res. Commun. 2019, 513, 201–206. [Google Scholar] [CrossRef] [PubMed]
- Darmstadt, G.L.; Mao, Q.M.; Chi, E.; Saha, S.K.; Ziboh, V.A.; Black, R.E.; Santosham, M.; Elias, P.M. Impact of topical oils on the skin barrier: Possible implications for neonatal health in developing countries. Acta Paediatr. 2002, 91, 546–554. [Google Scholar] [CrossRef] [PubMed]
- Zhang, X.C.; Zhang, P.J.; Rong, Y.T.; Lu, J.W.; Hua, H.B. Analysis of volatile components of Tricholoma matsutake and Agaricus blazei. Food Sci. 2019, 83, 1–13. [Google Scholar]
- Fu, B.B.; Meng, Q.F.; Li, X.F. A Self-Made Isolation Device of Morchella sp. ZL 201620445823.X. 2016. [Google Scholar]
- Barreiros, M.L.; Jesus, R.A.D.; Barreiros, A.L.B.S.; Sandes, T.S.; Ramalho, S.A.; Narain, N. Evaluation of the antioxidant activity of eight tropical fruits by DPPH method. Acta Hortic. 2018, 1198, 185–192. [Google Scholar] [CrossRef]
Sample Availability: Samples of the compounds are not available. |

| C1 | C2 | C3 | C4 | C5 | |
|---|---|---|---|---|---|
| α-d-ribopyranose | 94.3 | 70.8 | 71.1 | 681 | 63.3 |
| β-d-ribopyranose | 94.7 | 71.8 | 69.7 | 68.2 | 63.8 |
| α-d-ribofuranose | 97.1 | 71.7 | 70.8 | 83.8 | 63.3 |
| β-d-ribofuranose | 101.7 | 76.0 | 71.2 | 83.3 | 63.3 |
© 2019 by the authors. Licensee MDPI, Basel, Switzerland. This article is an open access article distributed under the terms and conditions of the Creative Commons Attribution (CC BY) license (http://creativecommons.org/licenses/by/4.0/).
Share and Cite
Yang, C.; Zhou, X.; Meng, Q.; Wang, M.; Zhang, Y.; Fu, S. Secondary Metabolites and Antiradical Activity of Liquid Fermentation of Morchella sp. Isolated from Southwest China. Molecules 2019, 24, 1706. https://doi.org/10.3390/molecules24091706
Yang C, Zhou X, Meng Q, Wang M, Zhang Y, Fu S. Secondary Metabolites and Antiradical Activity of Liquid Fermentation of Morchella sp. Isolated from Southwest China. Molecules. 2019; 24(9):1706. https://doi.org/10.3390/molecules24091706
Chicago/Turabian StyleYang, Cailing, Xuan Zhou, Qingfeng Meng, Mengjiao Wang, Yao Zhang, and Shaobin Fu. 2019. "Secondary Metabolites and Antiradical Activity of Liquid Fermentation of Morchella sp. Isolated from Southwest China" Molecules 24, no. 9: 1706. https://doi.org/10.3390/molecules24091706
APA StyleYang, C., Zhou, X., Meng, Q., Wang, M., Zhang, Y., & Fu, S. (2019). Secondary Metabolites and Antiradical Activity of Liquid Fermentation of Morchella sp. Isolated from Southwest China. Molecules, 24(9), 1706. https://doi.org/10.3390/molecules24091706
